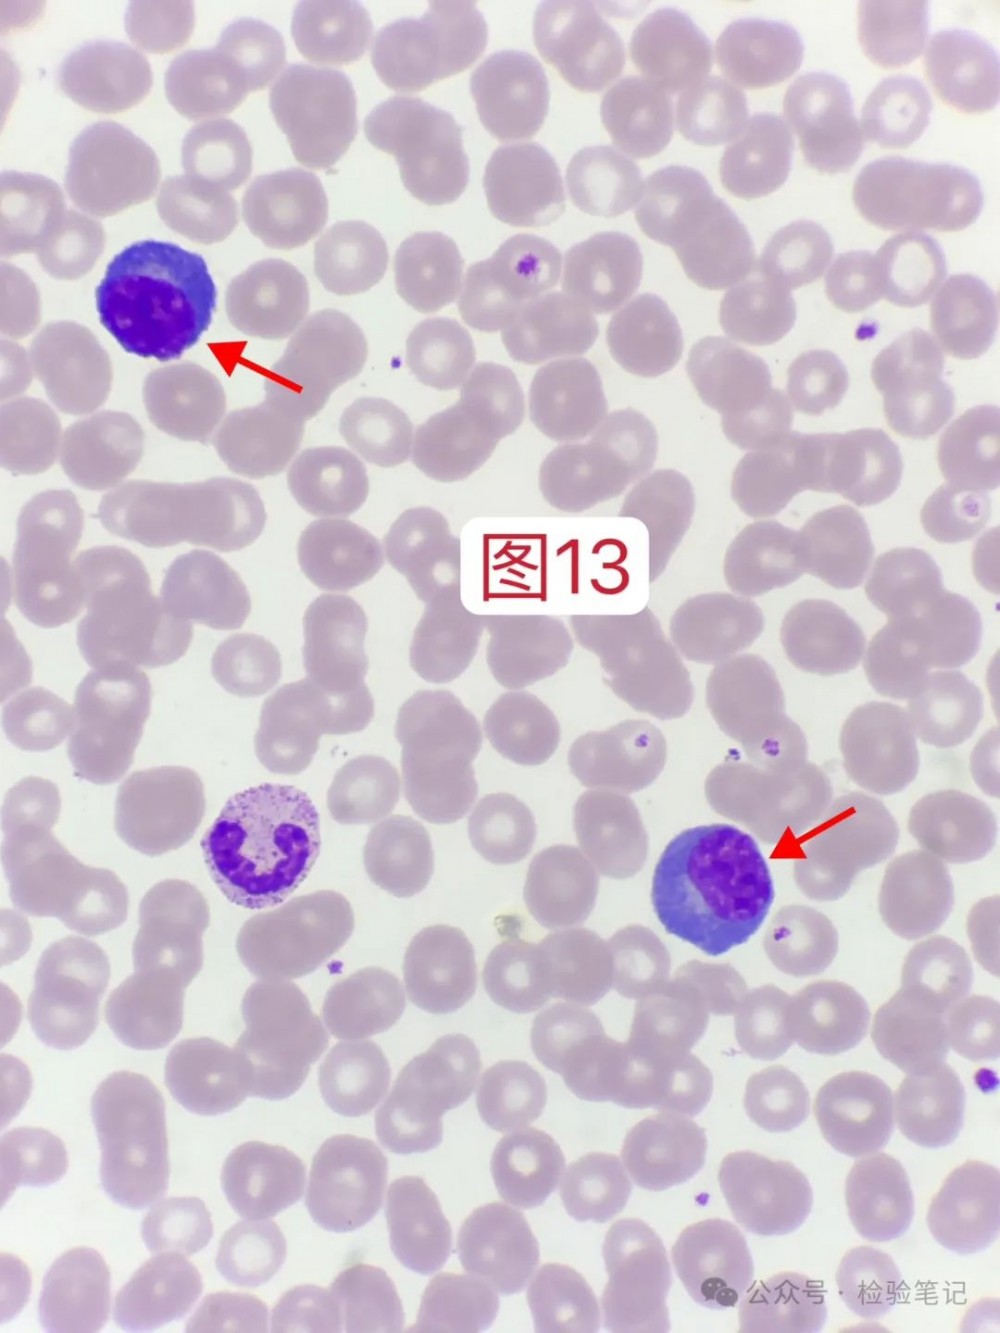
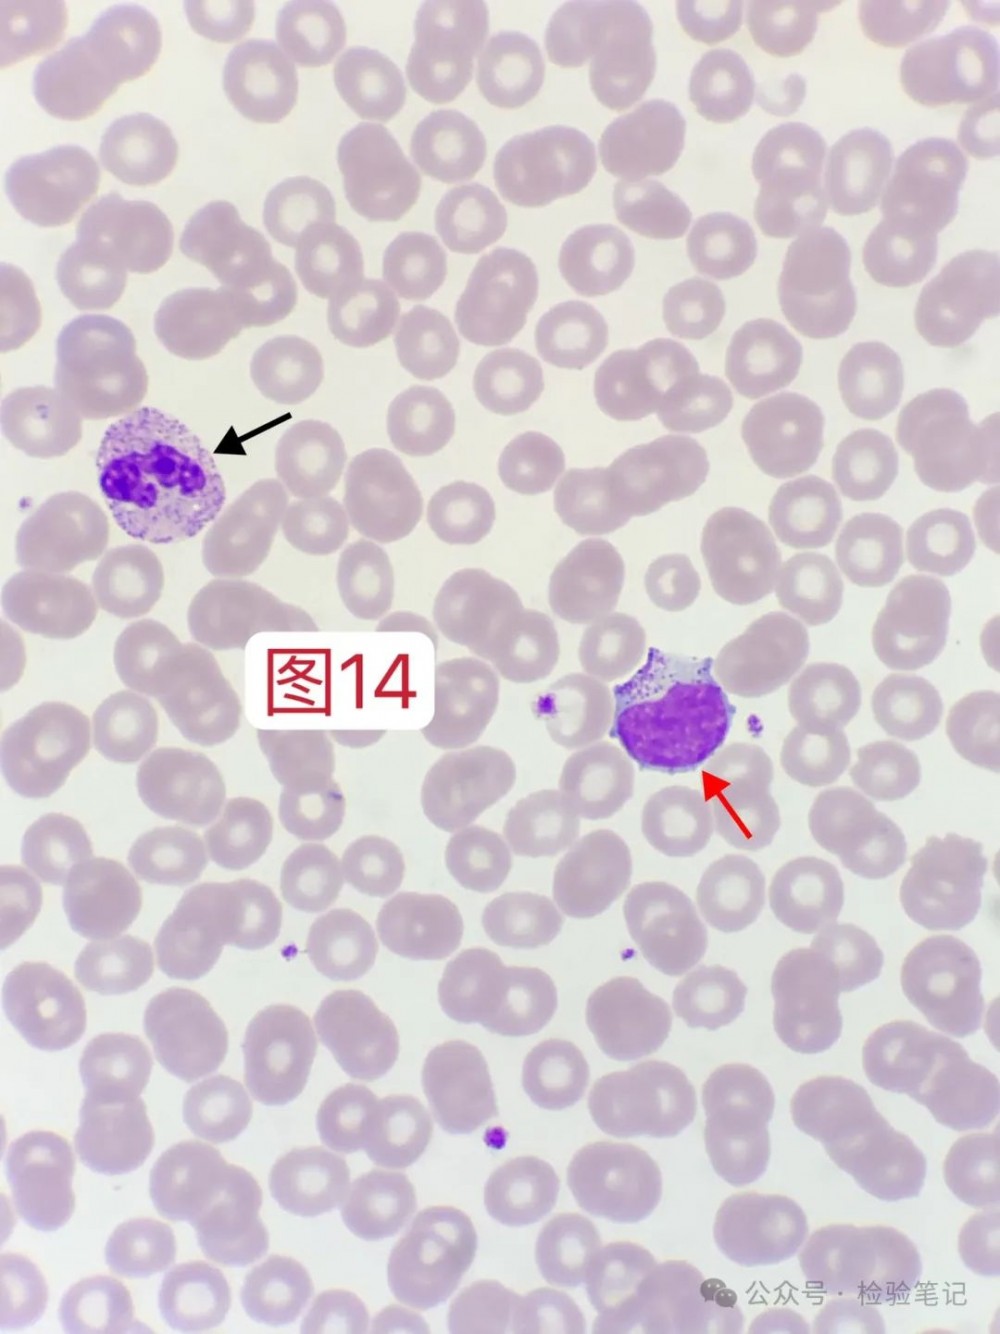
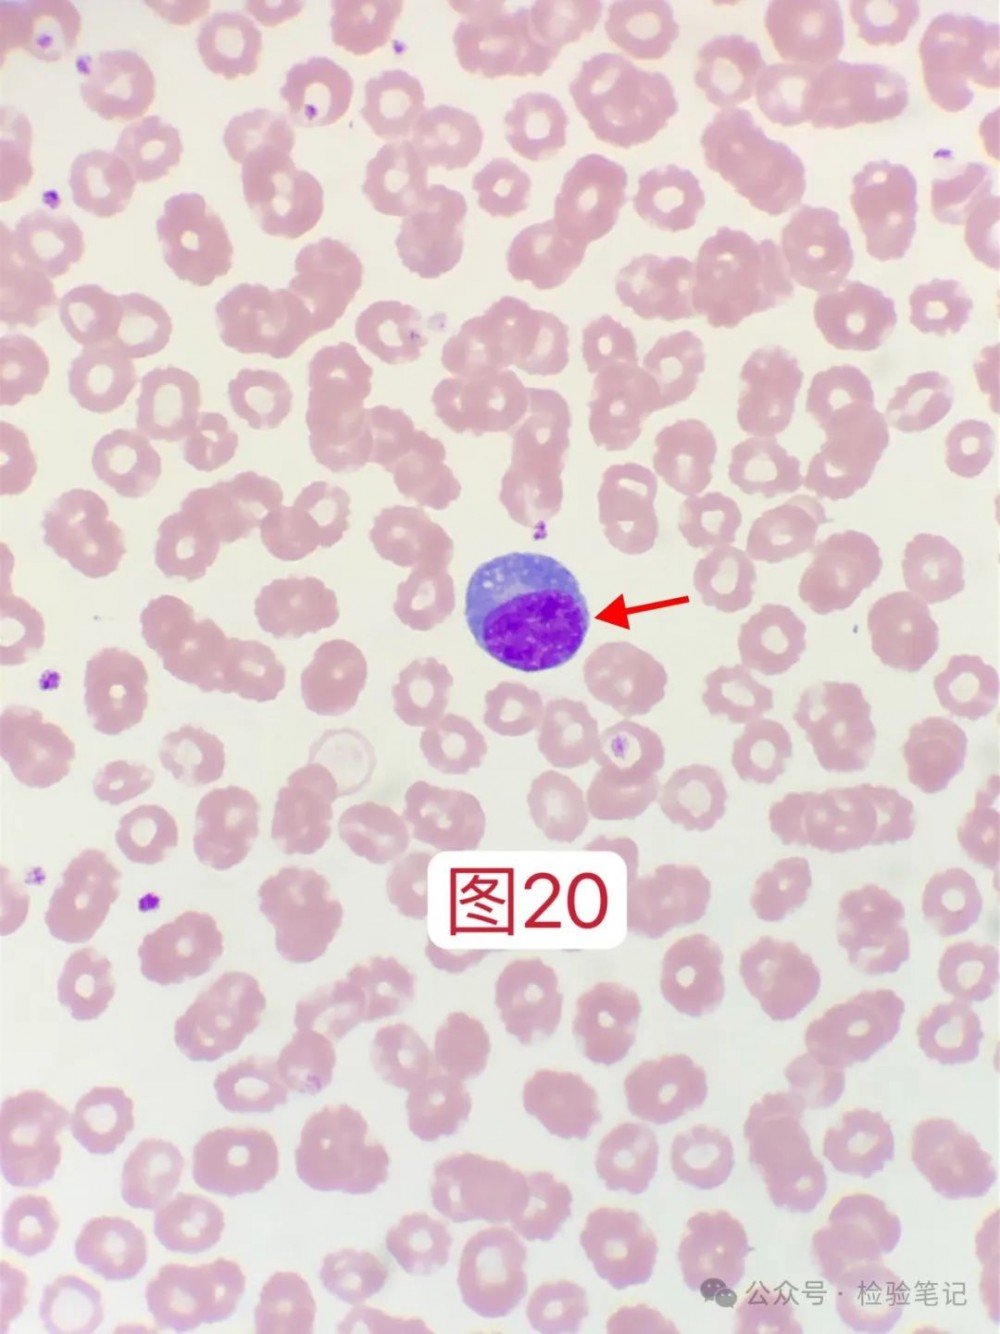
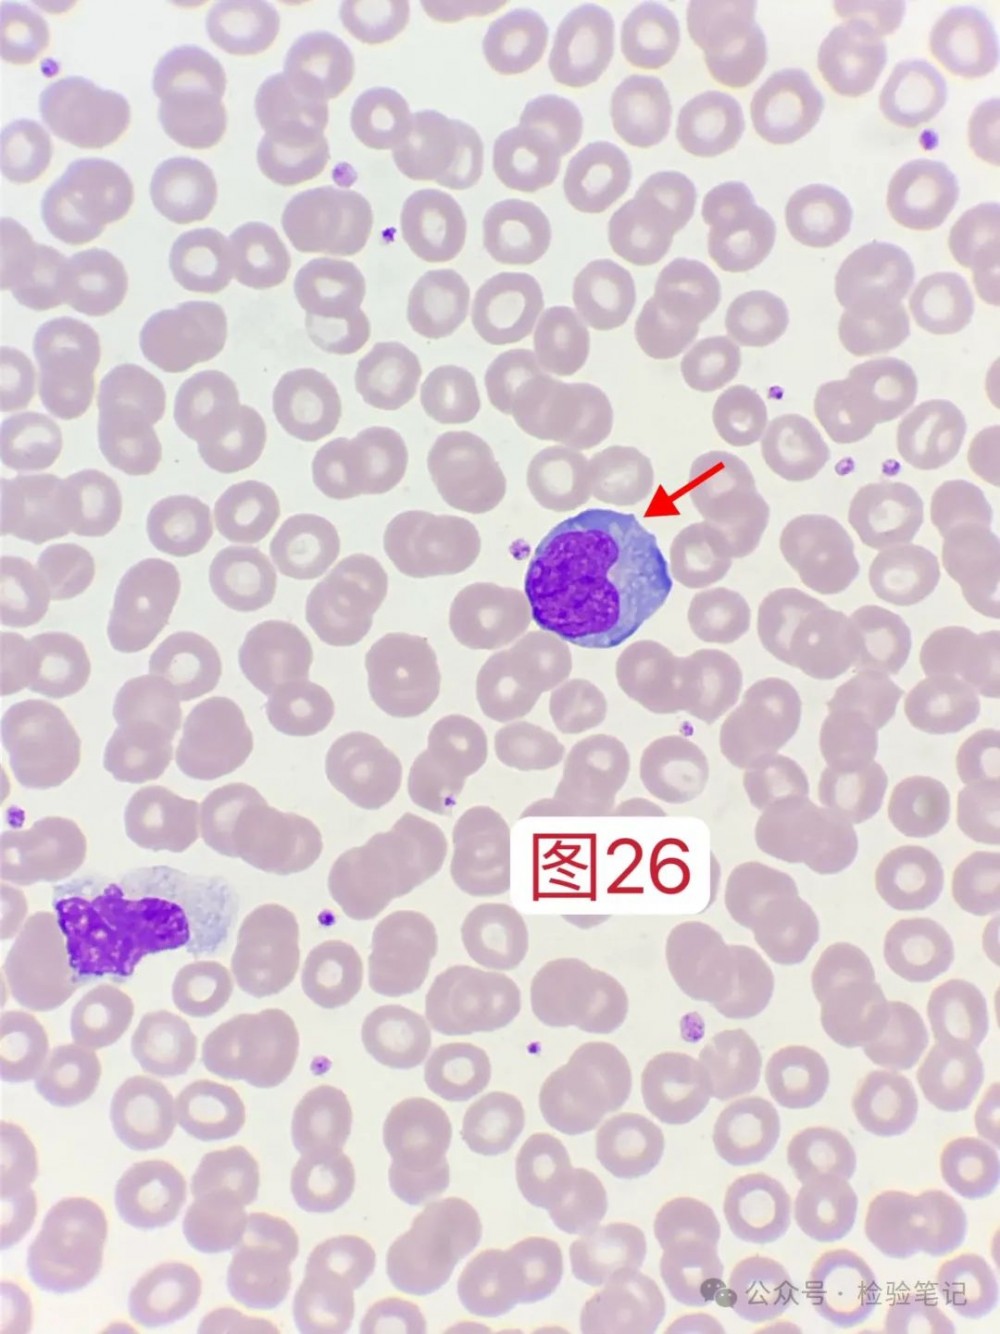
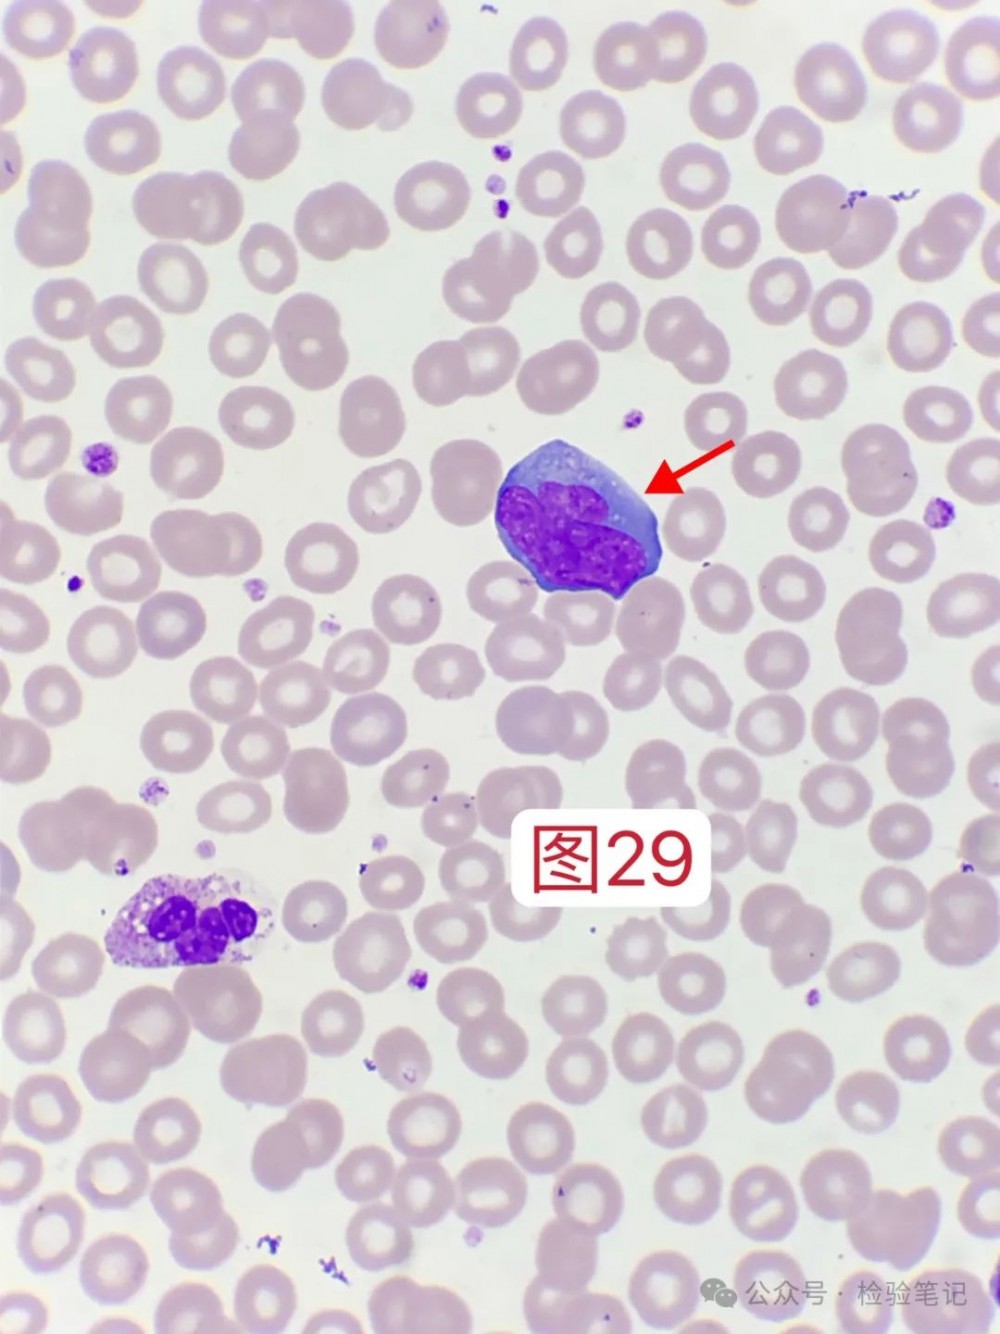

虫子咬一口,散点图都错乱了
前言
春夏季虫子较多,进入森林树木杂草、外出游玩、农田草丛间干活时,容易被蜱虫、恙虫叮咬,会表现出发热、血小板减少,血片能看到一些异型淋巴细胞。
本文将叙述一个被恙虫咬伤后住进ICU的故事。
注意:篇幅较长,为自己持续追踪的一个病例。

案例经过
8月2日,某患者,男,57岁,因“发热、消瘦、乏力”就诊于我院门诊。
血常规提示,WBC 3.22×10⁹/L,RBC 5.94×10¹²/L,HGB 159g/L,PLT 88×10⁹/L。

患者首次就诊,无历史结果对比,查看DIFF散点图,似乎有异常。
放大散点图。

淋巴细胞散点有上扬趋势,并且上扬的散点和单核细胞有点搅和在一起感觉。

Q-Flags提示,异型淋巴细胞报警阈值300,满格。
推片镜检。

红色:异型淋巴细胞,胞体大,大于4个红细胞体积,胞浆深蓝色,隐约可见核仁。此图拍摄于玻片一侧。
现在异淋统称为反应性淋巴细胞。
注意:反应性淋巴细胞包含范围更广,异型淋巴细胞只是反应性淋巴细胞中的其中一种。

红色:异型淋巴细胞

红色:异型淋巴细胞

红色:嗜碱性粒细胞,黑色颗粒较少,稀稀拉拉,可见黑色颗粒附着于胞核上。
黑色:血小板
血小板未见聚集,且散在分布,故考虑血小板为真性减少,报告异淋可见2-3个。
由于门诊信息极为有限,一时间我也找不到方向。
8月5日,发热加重入院,左腹股沟可触及肿大淋巴结,左腰部可见1cm黑色焦痂。
8月5日上午散点图如下,与8月2日基本差不多,PLT 45×10⁹/L。

8月6日下午散点图,可见淋巴上扬散点有点增多,PLT 57×10⁹/L。

由于患者仍然持续发热,且血压下降,考虑有脓毒性休克,会诊后转入重症监护室(ICU)。
8月7日上午散点图,淋巴上扬散点进一步增多,PLT 97×10⁹/L。

8月7日晚上散点图与当天上午基本差不多,PLT 131×10⁹/L。

接下来,重点来了。
8月8日上午,DIFF散点图异常奇怪,颜色竟然错乱了,PLT 167×10⁹/L。

放大散点图

白色:淋巴细胞散点,部分散点有上扬趋势
红色:单核散点竟然跑到淋巴细胞散点上方了?
黄色:少部分淋巴散点竟然分到了单核细胞散点区域?
太神奇了,第一见,推片看看什么情况。

红色:浆细胞样的反应性淋巴细胞(浆样淋,或者浆样异淋均可)

红色:浆细胞样的反应性淋巴细胞

红色:浆细胞样的反应性淋巴细胞
黑色:胞核圆形偏位
黄色:靠近胞核地方有白色的淡染区
红色:浆细胞样的反应性淋巴细胞
那这张片子有没有正常一点形态的淋巴细胞呢?
有的,请看↓
红色:含颗粒的淋巴细胞
黑色:含部分中毒颗粒的中性粒细胞

红色:浆细胞样的反应性淋巴细胞
所以,当看到单核细胞散点在淋巴细胞散点上面时候,需注意浆细胞可能。
当然也有老师分享,直接单核细胞散点冲顶的,也可能是浆细胞哦。
这就是散点图与镜下形态互相验证,总结规律,以后看到散点图便能猜出大概(虽然并不是100%完全正常)。
8月8日晚上,散点图跟上午基本一样,PLT 187×10⁹/L。

8月9日上午,散点图恢复了之前模样,PLT 222×10⁹/L。

放大散点图

红色:淋巴细胞散点又长又直,像火箭一样,冲顶了。

红色:反应性淋巴细胞

红色:反应性淋巴细胞
散点图颜色虽然恢复了之前的,但是浆样淋还是有的,多浏览视野还是能找到的。
红色:浆细胞样的反应性淋巴细胞,胞浆上都有少许空泡

红色:浆细胞样的反应性淋巴细胞

红色:浆细胞样的反应性淋巴细胞
8月9日晚上,散点图跟上午基本一致,PLT 220×10⁹/L。

8月10日晚上,淋巴细胞散点依旧上扬冲顶,但对比一下,可见上扬的散点开始变少了点。PLT 251×10⁹/L。

8月11日上午,淋巴细胞散点上扬,PLT 292×10⁹/L。

8月11日晚上,淋巴细胞散点上扬,明显冲顶的散点更少了,PLT 280×10⁹/L。

8月12日上午,PLT 329×10⁹/L。淋巴散点依旧有上扬。

放大散点图。

显然,上扬的散点更少了。
继续推片镜检。

红色:反应性淋巴细胞
黑色:大血小板
红色:反应性淋巴细胞(单核细胞型的异淋)

红色:反应性淋巴细胞(单核细胞型的异淋)

红色:反应性淋巴细胞(单核细胞型的异淋)
红色:反应性淋巴细胞(单核细胞型的异淋)

红色:反应性淋巴细胞(单核细胞型的异淋)
黑色:大血小板
黄色:涂抹细胞

红色:偶见的浆细胞样的反应性淋巴细胞
患者于8月12日转出ICU。
案例分析
8月2日,自己检见2-3个反应性淋巴细胞,线索有限,加上正常血片可以偶见一两个异淋,故当时并未重视。
8月5日患者住院后,直到8月7号,都是有反应性淋巴细胞,且细胞形态开始从不规则型异淋、幼稚型异淋往浆细胞型异淋增多。
并且在8月8号以浆细胞型异淋达到最多,导致了散点图的颜色变更(单核散点跑到了淋巴散点上面,部分淋巴散点跑到了单核散点区域)。
在8月9日时候,散点图颜色又变更回来了。这个时候开始,浆细胞型异淋开始逐渐减少,转向不规则型异淋增多,并于8月12日达到最多。
所以我就在想一个问题,当患者被蜱虫恙虫咬伤后血象出现血小板减少伴随浆细胞型异淋增多的过程中时候,是否就意味着病情逐渐加重呢?
而当血小板逐渐恢复,且浆细胞型异淋开始转变为不规则型异淋时候,就意味着病情的一个转归向良好趋势发展?
想到中科大附属第一医院的曾令军教授视频号里分享了比较多的蜱虫患者血涂片形态,且阅片机显示以浆细胞异淋多见,于是便请教曾主任一些问题。

从以上所有信息综合来看:蜱虫恙虫咬伤的患者预后,与病毒载量(估计得做PCR—DNA)、血小板数量恢复程度、就诊时间长短(拖得久就越严重,如本案例就是)、血片异淋形态分型,或许有着某种关联。
奈何,我手上的恙虫病例不够多。
提供个思路,这是个很好的课题或者论文方向。前提是你得有足够多的蜱虫或恙虫病例数量,至于病毒载体量,有则更有说服力,没有的话,应该也能发文章。
从本案例来看,血小板恢复的速度是快于浆细胞型异淋的,或者说,血小板数量已经升上来了,浆样型异淋才姗姗来迟占据主导地位。
随着病情转归,浆样型异淋会逐渐下降。
这也是自己在群里看到某位形态老师讲过的,外周血看到比较多的浆细胞型异淋,往往是不太好的现象。
实践出真知,又一次在工作中验证了别的老师总结的经验。
知识拓展
焦痂是恙虫病的特征之一,大部分有淋巴结肿大。
内容来源 | 检验笔记
图片来源 | veer、ibaotu
排版 | znm
审校 | 金宝

